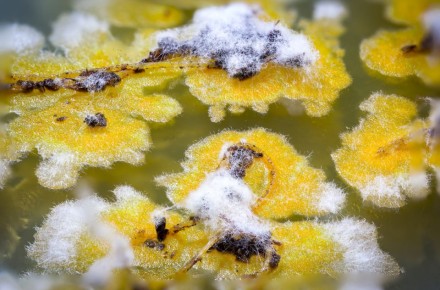
����� � ��������: ����������� �������� ��� ������ ���� � �������

Переменная облачность прогнозируется в Удмуртии во вторник, 31 марта
«Преимущественно без осадков. Ветер северо-восточный, восточный 2-7 м/с. Температура воздуха днём +12…+17°С». — говорится в сообщении пресс-службы ГУ МЧС по республике.
Утром местами гололедица.
Фото: ИИ